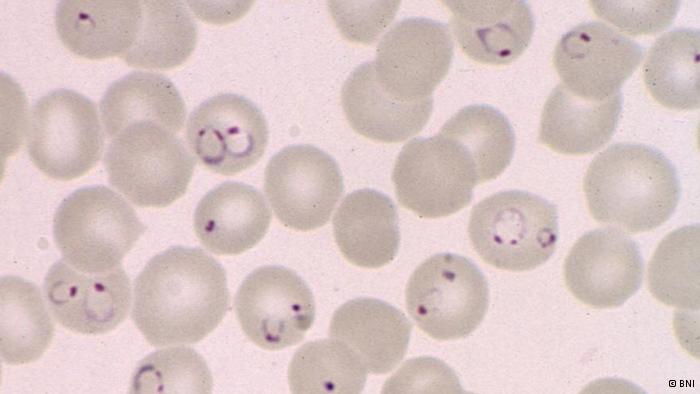

(Reuters) – Partners Toshiba Corp of Japan and SanDisk Corp of the United States separately filed civil lawsuits against South Korea’s SK Hynix Inc, seeking damages over the suspected theft of data related to their flagship flash memory chip technology used in smartphones and tablet computers. SK Hynix said on Friday it had not yet received the litigation and had no comment to make. Hynix competes with both Toshiba and SanDisk, partners in flash memory […]
Life
Facebook CEO Zuckerberg phoned Obama to complain about spying
(Reuters) – Facebook Inc Chief Executive Mark Zuckerberg blasted the U.S. government’s electronic surveillance practices on Thursday, saying he’d personally called President Barack Obama to voice his displeasure. “When our engineers work tirelessly to improve security, we imagine we’re protecting you against criminals, not our own government,” Zuckerberg said in a post on his personal Facebook page. “I’ve called President Obama to express my frustration over the damage the government is creating for all of […]
Tokyo police to probe leak of Toshiba chip technology: paper
(Reuters) – Tokyo police will probe a suspected leak of Toshiba Corp technology to a South Korean company that relates to the top Japanese chipmaker’s flagship memory chips, the Yomiuri newspaper reported on Thursday. The paper also said police had obtained a warrant for the arrest of a former engineer at a Toshiba-affiliated chipmaker who was suspected of improperly providing technical data to SK Hynix Inc. A Toshiba spokesman said the company could not comment […]
The technologies behind the search for Malaysia Airways Flight 370
Radar, radio and sonar can all be used to locate missing planes. Now, a crowdsourcing initiative is allowing regular people to comb satellite images in to the search for flight MH370, which went missing last Saturday. What’s known is this: Contact was lost with Malaysia Airways Flight 370 about an hour after takeoff from Kuala Lumpur en route to Beijing. But the details of the case are shrouded in mystery: Why were two passengers traveling […]
Using viruses to fight cancer
It sounds like a promising way to fight cancer: viruses that kill tumor cells. But can the crazy idea really work? DW met some German scientists who think so. Viruses can infect and proliferate inside cancer cells in a process known by scientists as oncolysis: “By means of this proliferation, the cancer cells are effectively killed,” explains Ulrich Lauer of the Tübingen University medical clinic. This process was first observed well over 100 years ago: […]
Scientists develop microscopy system for diagnosing malaria faster
Diagnosing malaria with a microscope isn’t easy. Not only does it take time, but a lot of practice is needed. A team of German researchers has now made a machine that could help. The Fraunhofer Institute for Integrated Circuits has been developing a prototype of an automated microscopy system to diagnose malaria. A white box containing a microscope is linked to a computer, and all a medical assistant has to do is introduce a cartridge […]
World Wide Web on its 25th Anniversary
Happy 25th Birthday World Wide Web! Today, people from across the globe are joining Tim Berners Lee in – the man who changed the way how world communicate, wishing the World Wide Web a happy 25th birthday. World Wide Web made our life a lot more easier in so many ways, admit it, am sure you do. Since the beginning of W3, information was never been a hassle to us searchers. Whenever we are looking […]
Infographics: How To Ace Your Final Exams
Ace Your Final Exams With Flying Colors By: Natalie Kate Ann Juntado Finals are knocking and you saw it coming already. Don’t sweat, just be cool. Final exams should be taken seriously, but not in a painful process. Always look on the brighter side and remember finals need an extra preparation. Start planning ahead and maximize your time reviewing your old notes and attempt to manage your time to study from the most important/hard subject […]
Let’s Get To Know Larry Tesler; The Guy Who Invented ‘Copy and Paste’
In celebration of the 25th anniversary of the World Wide Web, this coming March 12, 2014, let us get to know the man behind the most powerful and used technique that saves our freaking life in school and work everyday, Larry Tesler; the guy who invented the ever useful ‘Copy and Paste’. Lawrence Gordon Tesler was born on April 24, 1945, a computer science graduate from Standford University in the 1960’s. Lester is a […]
Luxury Driverless Concept Car Offers View To The Future
(Reuters) — With the era of driverless cars getting nearer, Swiss automotive think-tank Rinspeed have offered their take on our autonomous driving future at this week’s Geneva Car Show. With the help of a female model’s feminine touch, the futuristic Rinspeed XchangE Autonomous Prototype has been a popular attraction at the 2014 show. Based around the Tesla Model S but featuring a large array of modifications, at first sight, the XchangE car looks like many of the other expensive modern cars on display at the show. […]
Youngest person to build a nuclear reactor
Jamie Edwards, a 13-year old scientist in England, was declared as the “youngest person to build an nuclear reactor”.
Internet Slang Terms That Changed The World
Internet Slang Terms You Need To Know Keeping updated with the latest internet terms and lingo words are quite tough especially if you are the kind of the person who is not an internet savvy. But did you know communication has changed in so many ways in the world wide web? Netizens today are creative; being able to form a phrase that somewhat useful in everyday’s interaction. Internet slang terms are going viral, […]